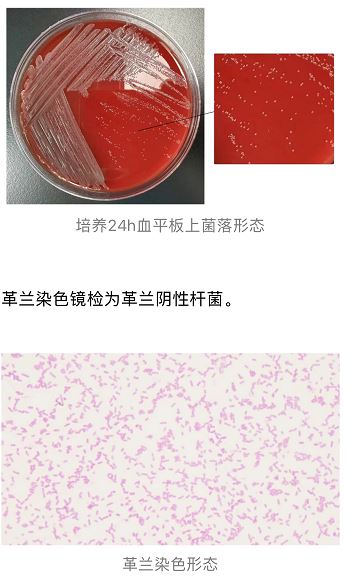
1773628992177808.jpg 1773628992177808.jpg
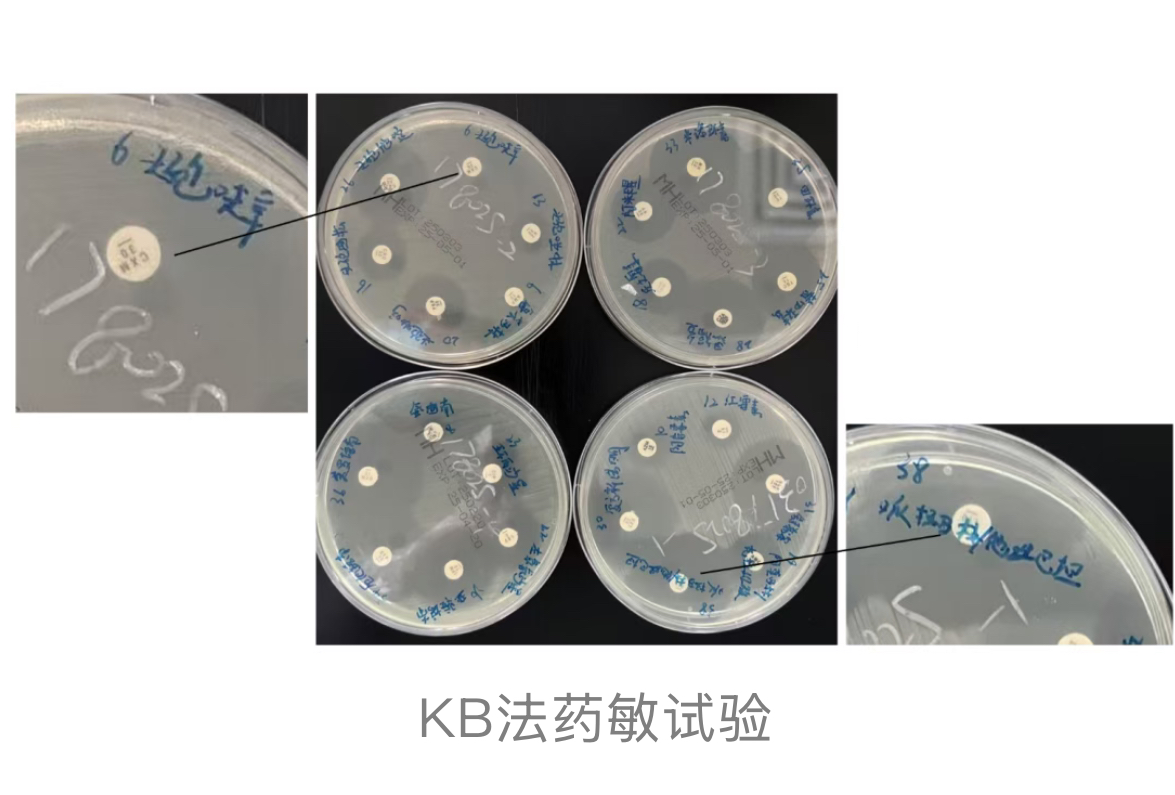
1773629002847960.jpg 1773629002847960.jpg

稀有无色杆菌“突袭”创伤伤口,看实验室如何精准“狙击”
作者:关艺琳,张艳玲
,方容,余展鹏等,广州医科大学附属第五医院
在临床检验工作中,较少分离出稀有无色杆菌,该菌可引发皮肤及软组织感染,尤其是近期出现创伤的患者。由于稀有无色杆菌暂无药敏参考标准,因此需结合患者的基础病情谨慎选择抗生素。
案例经过
主要病史
患者女,62岁,1周前不慎摔伤致右小腿疼痛、流血,创面较深,可见肌肉、血管,予清创缝合术后1周皮缘局部坏死,伴渗液,无头晕、头痛
、恶心、呕吐
、四肢抽搐。既往史及个人史无特殊。
专科检查
右小腿可见开放性创面,较深,可见肌肉、血管,伴渗液,皮肤裂伤呈“L”形,裂伤皮缘瘀紫,皮温稍高,关节无红肿、活动自如,左下肢无浮肿。四肢肌力Ⅴ级,肌张力
正常,双侧肱二、三头肌腱反射正常,双侧膝、跟腱反射正常,Hoffmann征阴性、Babinski征阴性、Kernig征阴性。
临床诊断
右下肢软组织感染。
细菌培养及鉴定
患者行右小腿清创VSD术并取渗液标本送检,经24h培养,血平板上可见灰色较湿润的圆形菌落。
采用MALDI-TOF MS进行鉴定,但由于仪器数据库中该菌株的图谱信息不全面或缺乏,导致鉴定评分较低(如<2.00),无法给出高置信度的鉴定结果。随即送16S rRNA基因测序,结果为稀有无色杆菌(Achromobacter insolitus)。
诊疗经过
患者分别于2025年3月3日、3月10日和3月17日行右下肢清创缝合、皮瓣转移、VSD引流术,术中均取渗液标本送检,分别于3月6日和3月13日报告有稀有无色杆菌生长。
由于该菌没有药敏参考标准,经与管床医生沟通,该患者目前正使用头孢呋辛
抗感染治疗,治疗效果不佳,临床强烈需要药敏结果协助指导抗生素的使用。因此,实验室使用KB法进行药敏检测,可见头孢呋辛纸片周围无抑菌圈,说明临床使用头孢呋辛无效,发现哌拉西林/他唑巴坦
纸片周围有明显抑菌圈,直径达38mm,建议临床医生更换哌拉西林/他唑巴坦。
患者经过3次清创治疗和联合使用哌拉西林/他唑巴坦治疗,创伤部伤口干洁,无渗液,创面愈合可。
案例分析及知识拓展
稀有无色杆菌是无色菌属中的一种菌种[1],是革兰阴性需氧杆菌,广泛分布于自然环境中,但临床感染较为罕见。
本例患者因外伤后右小腿开放性创面感染稀有无色杆菌,其临床特点与文献报道的皮肤及软组织感染(SSTIs)表现相似,即创伤后伤口迁延不愈、渗液及局部炎症反应[2-3]。该菌的致病机制可能与创伤后局部免疫屏障破坏、细菌黏附及生物膜形成有关,但具体毒力因子仍需进一步研究。
本病例的诊断依赖于细菌培养及药敏试验
。通过多次清创术中渗液标本的培养,结合菌落形态、革兰染色、质谱及测序技术,最终鉴定为稀有无色杆菌。
值得注意的是,由于该菌缺乏标准药敏试验指南,临床治疗面临挑战。本病例中,临床医生初始经验性使用头孢呋辛效果不佳,可能与其对产β-内酰胺酶
菌株的抗菌活性有限有关。后续通过KB法药敏试验发现哌拉西林/他唑巴坦(β-内酰胺酶抑制剂复合制剂)具有显著抑菌效果,更换药物后患者创面迅速愈合。这一结果提示,对于产酶菌株,含酶抑制剂的广谱抗生素可能是更优选择。
在治疗策略方面,本病例的成功得益于多模式干预:1. 彻底清创联合负压封闭引流 VSD有效减少了细菌负荷和坏死组织;2. 根据药敏结果及时调整抗生素,体现了精准治疗的重要性。此外,稀有无色杆菌的耐药性可能因地域和菌株差异而不同,因此个体化药敏检测在少见菌感染中至关重要。
目前,稀有无色杆菌的药敏数据有限,临床亟需建立标准化的检测方法及耐药性数据库。未来研究可聚焦于该菌的流行病学特征、耐药基因谱及与临床预后的相关性,以指导抗生素选择。同时,临床医生需提高对少见菌感染的警惕性,尤其在创伤或免疫功能低下患者中,应加强微生物学检测与多学科协作,避免延误治疗。
案例总结及点评
本文报告了一例由稀有无色杆菌引起的创伤相关软组织感染案例。该菌临床分离率极低,既往多见于环境样本或个别基础疾病患者,对其致病性与抗菌药物敏感性仍缺乏系统认识。此次能明确分离并确认其为感染病原,具有较高的临床参考价值。
在病原识别过程中,实验室首先采用MALDI-TOF MS进行初步鉴定,但由于质谱得分偏低,鉴定结果可信度不足,无法作为最终依据。为进一步明确病原体信息,随即开展16S rRNA基因测序,结果显示为Achromobacter insolitus,结合菌落特征与革兰染色形态,最终确认该菌为病原菌。这一过程体现了在面对此类“数据库未覆盖或结果置信度不足”的罕见微生物时,实验室应具备规范的验证思维和鉴定能力。
值得一提的是,由于该菌尚无CLSI或EUCAST推荐的药敏断点,临床在初始使用头孢呋辛治疗后疗效不佳,急需实验室提供可参考的药敏信息。团队及时开展纸片扩散试验,发现哌拉西林/他唑巴坦对该菌株具有明确的抑菌活性,而头孢呋辛则完全无效。这一发现直接促使临床调整治疗方案,配合连续清创与VSD引流,最终实现伤口控制与创面愈合,体现了微生物检测结果在感染管理中的重要指导价值。
此外,该病例也凸显了当前临床微生物检测中对少见病原体处置策略尚不完善的问题。面对数据库无法准确覆盖、药敏折点缺失等现实限制,实验室需具备对低可信度鉴定结果的识别能力,并及时采取包括分子测序在内的补充鉴定手段,以确保鉴定结果的准确性与可靠性。对于此类缺乏明确药敏判断依据的菌株,药敏结果的解释应综合考虑纸片扩散试验的抑菌圈直径、肉汤稀释法的MIC值、药代动力学/药效学特性,以及感染部位和患者的基础状况,避免因缺乏参考标准而导致用药延误或判断失误。
综上所述,本病例充分展示了实验室在面对罕见病原体、缺乏标准药敏参考、以及经验治疗无效等多重复杂因素影响下,依然能够迅速作出判断、灵活调整技术路径,并为临床提供精准有效的诊断支持。这种应对能力不仅直接关系到患者感染控制与预后改善,也体现出微生物实验室在感染性疾病诊疗体系中的关键作用。通过本病例的总结分析,有助于进一步深化对稀有无色杆菌的潜在临床意义的认识,也为今后完善相关检验流程与应急响应体系提供了实践参考。
【参考文献】
[1] Ridderberg W, Wang M, Nørskov-Lauritsen N.Multilocus sequence analysis of isolates of Achromobacter from patients with cystic fibrosis reveals infecting species other than Achromobacter xylosoxidans[J].Journal of clinical microbiology, 2012, 50 (8) :2688-2694.
[2] Fung HB,Chang JY,Kuczynski S. A practical guide to the treatment of complicated skin and soft tissue infections[J].Drugs,2003,63(14):1459-1480.
[3]Morrison SM,Blaesing CR,Millar EV,et al.Evaluation of methicillin-resistant Staphylococcus aureusskin and soft-tissue infection prevention strategies at a military training center[J].Infect Control Hosp Epidemiol,2013,34(8):841-843.
来源:检验医学网